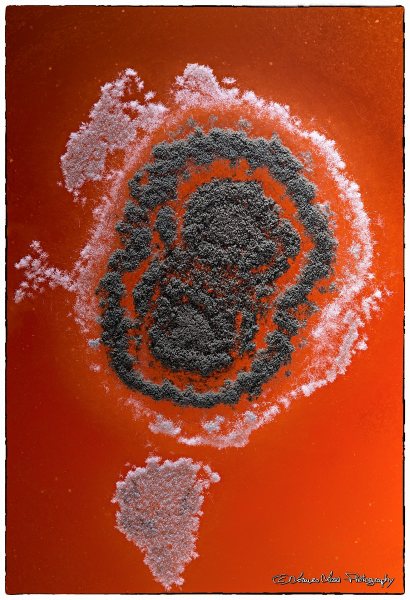
Foto

| Accetta Cookie | Personalizza | Rifiuta Cookie |
|

Tutte le foto contenute in queste gallerie sono copyright L.lorenzo e non possono essere utilizzate in alcuna forma senza il consenso dell'autore.
 JuzaPhoto contiene link affiliati Amazon ed Ebay e riceve una commissione in caso di acquisto attraverso link affiliati.
JuzaPhoto contiene link affiliati Amazon ed Ebay e riceve una commissione in caso di acquisto attraverso link affiliati.Possa la Bellezza Essere Ovunque Attorno a Me